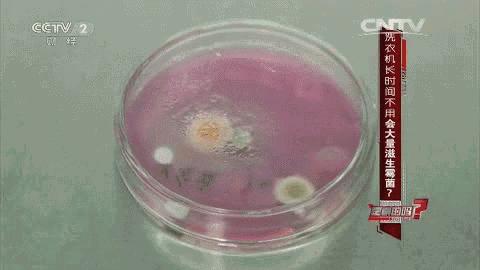
衣服洗完有脚臭味怎么办,洗完的衣服有腥气味是怎么回事

家里用得最频繁的家电就是洗衣机了
毕竟一天一小洗,三天一大洗……
洗啊洗,根本没停过

时间久了是不是发现,
明明刚从洗衣机洗出来的衣服,
上面还有灰色的污垢?
刚用洗衣液洗了一遍,
穿在身上一股酸臭味?
其实这些都是洗衣机长时间不清洗导致的!
有一个大部分人都不知道的冷门知识:
洗衣机若一年内不清理,
将比马桶脏 500 多倍!
一定有很多人不相信
毕竟家里的洗衣机看起来都很干净啊!

小编很负责任地告诉你,那只是“看起来”而已。
高能预警!拆开后内筒脏到你无法想象!

一般情况下,
新洗衣机在使用5个月后,
污垢开始堆积,细菌开始增多,
表面看起来洗衣机不会有什么,
但是拆开来看,就可以见证奇迹的发生……

赶紧回家看看你家里的洗衣机,如果下水回路这里地方都能看见霉菌,洗衣槽可想而知有多脏了!

洗衣机会“脏”到什么程度?

许多人认为,洗衣机清洗衣物后,本身也应该干净了。但相关研究指出,洗衣机使用愈久,洗衣次数愈频繁,洗衣槽里的霉菌孢子数量就越多,进而附着于衣物上造成二次污染。
长时间使用的洗衣机中,藏着多少细菌?央视“是真的吗”栏目曾经做过一次调查。

检测技术人员对一周未使用、两周未使用、两个月未使用的洗衣机进行实验。

工作人员对洗衣水进行采样发现,一周未使用的洗衣机里面每毫升有5个菌落,两周未用的洗衣机里面每毫升有6个菌落,两个月未使用的洗衣机里面菌落数多不可计。
疾控中心曾对大量使用过半年以上的洗衣机做了一次细菌污染情况抽样调查,结果发现,洗衣机中的细菌总数超标率高达80%以上,大肠菌群检查率为100%,霉菌的检出率约为60%。

洗衣机里面竟然藏有一个庞大的细菌群!这种细菌群是由自来水里的水垢、洗衣粉的游离物、衣物的纤维素、人体的有机物及衣物带入的灰尘与细菌组成的。
这就是为什么说,
如果不清洁洗衣机,
它的细菌量是马桶的500倍!
这些细菌对我们有哪些危害?

- 洗衣时,这些霉菌随着水流散布并污染衣物,最后传到人体上,可能会导致人们皮肤瘙痒、过敏,甚至诱发皮炎。
- 同时还会造成二次污染,这个问题已经成为女性感染妇科病的“头号凶手”。所以,我们的小裤裤是坚决不能进洗衣机里清洗的,不能给霉菌任何可乘之机。
- 不仅如此,洗衣机里的细菌对家里老人、宝宝都有一定的影响,霉菌是真菌,真菌和细菌一样能够致病,导致人体感染。

平常宝宝起皮疹什么的,除了环境和自身体质因素 ,很有可能是因为洗衣机清洁工作没到位产生的。所以定期对洗衣机进行清洗 消毒杀菌是必不可少的!

洗完的衣服穿在身上为何有股酸臭味?
您知道了么?
百洁帮 一切为了您 和家人的健康!
